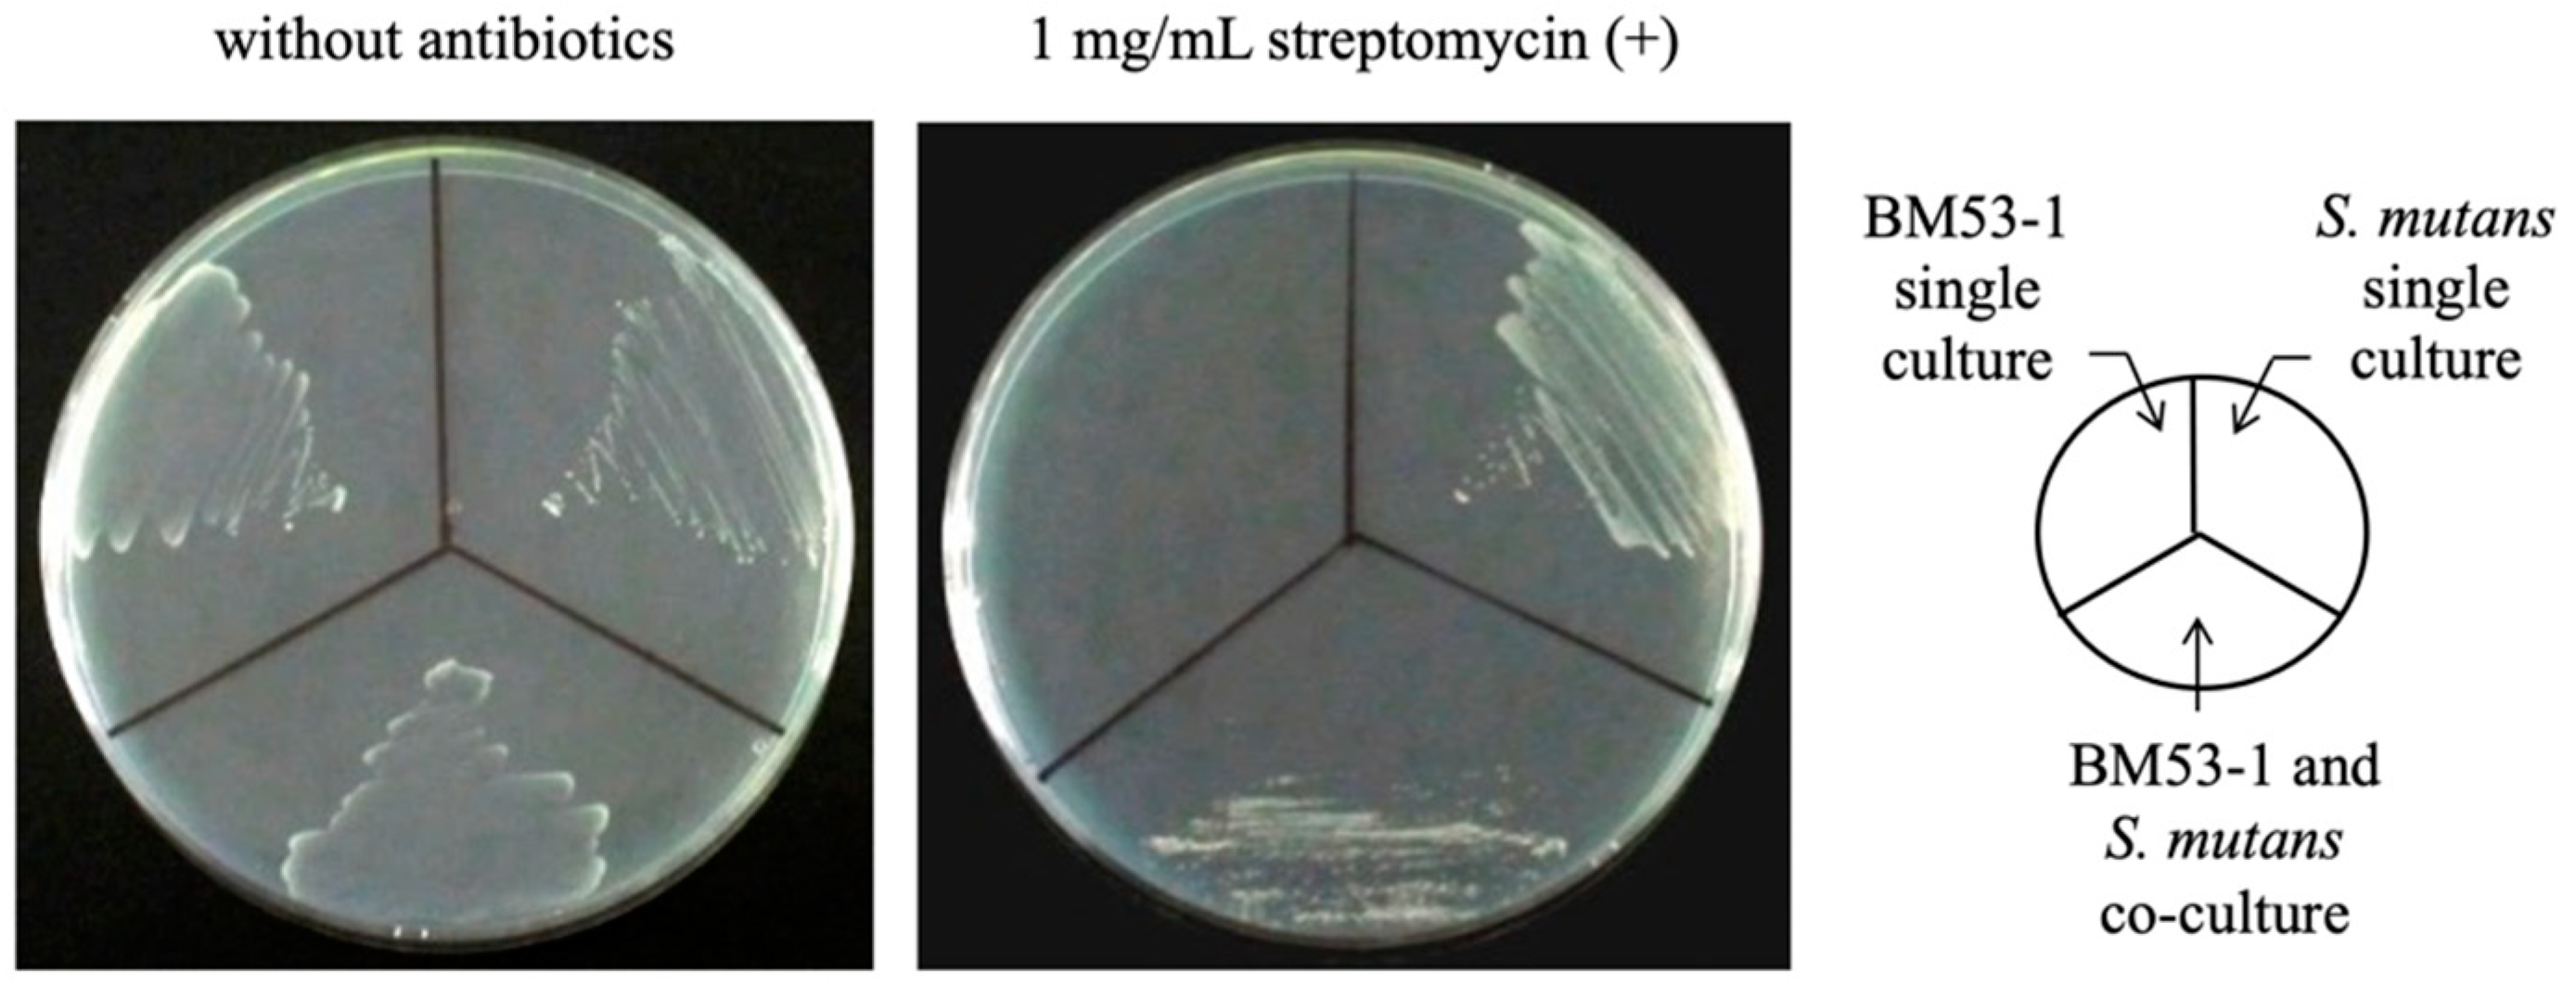
Microorganisms 09 01390 g002

Lactobacillus reuteri BM53-1 Produces a Compound That Inhibits Sticky Glucan Synthesis by Streptococcus mutans
Abstract
:1. Introduction
2. Materials and Methods
2.1. Bacterial Strains and Culture Conditions
2.2. Assay Method for Anti-Glucan-Forming Activity
2.3. Chromosomal DNA Preparation and LAB Strain Identification
2.4. Preparation of the GI Fraction from the BM53-1 Strain Culture Broth
2.5. Scanning Electron Microscopy (SEM) Analysis
2.6. Acute Oral Toxicity Test
2.7. Bacterial Reverse Mutation Test (Ames Test)
2.8. RNA Extraction and qRT-PCR Analysis
2.9. Analyses of the GI Molecular Mass
2.10. Analyses of Each Monosaccharide Contained in the GI
3. Results
3.1. Isolation of the GI-Producing LAB Strain
3.2. Confirmation of the Bactericidal Activity of the BM53-1 Strain
3.3. Safety Evaluations of BM53-1 for Food Manufacture
3.4. Effect on the GTF Gene Expression of S. mutans
3.5. SEM Analyses of the Morphology of S. mutans Cells in the Presence or Absence of the GI
3.6. Characteristics of the GI Prepared Using the Exopolysaccharide (EPS)-Purification Method
4. Discussion
5. Conclusions
Supplementary Materials
Author Contributions
Funding
Institutional Review Board Statement
Informed Consent Statement
Data Availability Statement
Acknowledgments
Conflicts of Interest
References
- Cury, J.A.; Tenuta, L.M. Enamel remineralization: Controlling the caries disease or treating early caries lesions? Braz. Oral Res. 2009, 23 (Suppl. 1), 23–30. [Google Scholar] [CrossRef] [Green Version]
- Featherstone, J.D. Dental caries: A dynamic disease process. Aust. Dent. J. 2008, 53, 286–291. [Google Scholar] [CrossRef] [PubMed]
- Nicolae, V.; Neamtu, B.; Picu, O.; Martu-Stefanache, M.A.; Ibric Cioranu, V.S. The comparative evaluation of salivary biomarkers (calcium, phosphate, salivary pH) in cario-resistance versus cario-activity. Rev. Chim. 2016, 68, 821–824. [Google Scholar]
- Brazen, B.; Dyer, J. Histology, salivary glands. In StatPearls (Internet); StatPearls Publishing: Treasure Island, FL, USA, 2021. [Google Scholar]
- Lendenmann, U.; Grogan, J.; Oppenheim, F.G. Saliva and dental pellicle—A review. Adv. Dent. Res. 2000, 14, 22–28. [Google Scholar] [CrossRef]
- Hannig, C.; Hannig, M.; Attin, T. Enzymes in the acquired enamel pellicle. Eur. J. Oral Sci. 2005, 113, 2–13. [Google Scholar] [CrossRef]
- Koo, H.; Falsetta, M.L.; Klein, M.I. The exopolysaccharide matrix: A virulence determinant of cariogenic biofilm. J. Dent. Res. 2013, 92, 1065–1073. [Google Scholar] [CrossRef] [Green Version]
- de Soet, J.J.; Holbrook, W.P.; Magnusdottir, M.O.; de Graaff, J. Streptococcus sobrinus and Streptococcus mutans in a longitudinal study of dental caries. Microb. Ecol. Health Dis. 1993, 6, 237–243. [Google Scholar] [CrossRef] [Green Version]
- Colby, S.M.; Russell, R.R.B. Sugar metabolism by mutans streptococci. J. Appl. Microbiol. Symp. Suppl. 1997, 83, 80S–88S. [Google Scholar] [CrossRef]
- Ryan, K.J.; Ray, C.G. Sherris Medical Microbiology, 4th ed.; McGraw Hill: New York, NY, USA, 2003. [Google Scholar]
- Huang, R.; Li, M.; Gregory, R.L. Bacterial interactions in dental biofilm. Virulence 2011, 2, 435–444. [Google Scholar] [CrossRef]
- Matsumoto-Nakano, M. Role of Streptococcus mutans surface proteins for biofilm formation. Jpn. Dent. Sci. Rev. 2018, 54, 22–29. [Google Scholar] [CrossRef]
- Cotter, P.D.; Hill, C.; Ross, R.P. Bacteriocins: Developing innate immunity for food. Nat. Rev. Microbiol. 2005, 3, 777–788. [Google Scholar] [CrossRef] [PubMed]
- Adolfsson, O.; Meydani, S.N.; Russell, R.M. Yogurt and gut function. Am. J. Clin. Nutr. 2004, 80, 245–256. [Google Scholar] [CrossRef] [PubMed]
- Cross, M.L.; Stevenson, L.M.; Gill, H.S. Anti-allergy properties of fermented foods: An important immunoregulatory mechanism of lactic acid bacteria? Int. Immunopharmacol. 2001, 1, 891–901. [Google Scholar] [CrossRef]
- Heyman, M. Effect of lactic acid bacteria on diarrheal diseases. J. Am. Coll. Nutr. 2000, 19 (Suppl. 2), 137S–146S. [Google Scholar] [CrossRef]
- Meydani, S.N.; Ha, W.K. Immunologic effects of yogurt. Am. J. Clin. Nutr. 2000, 71, 861–872. [Google Scholar] [CrossRef] [PubMed] [Green Version]
- Ahumada, M.C.; Bru, E.; Colloca, M.E.; López, M.E.; Nader-Macías, M.E. Evaluation and comparison of lactobacilli characteristics in the mouths of patients with or without cavities. J. Oral Sci. 2003, 45, 1–9. [Google Scholar] [CrossRef] [PubMed]
- Ishikawa, H.; Aiba, Y.; Nakanishi, M.; Oh-Hayashi, Y.; Koga, Y. Suppression of periodontal pathogenic bacteria in the saliva of humans by the administration of Lactobacillus salivarius TI 2711. J. Jpn. Soc. Periodontal. 2003, 45, 105–112. [Google Scholar] [CrossRef] [Green Version]
- Nikawa, H.; Tomiyama, Y.; Hiramatsu, M.; Yushita, K.; Takamoto, Y.; Ishi, H.; Mimura, S.; Hiyama, A.; Sasahara, H.; Kawahara, K.; et al. Bovine milk fermented with Lactobacillus rhamnosus L8020 decreases the oral carriage of mutans streptococci and the burden of periodontal pathogens. J. Investig. Clin. Dent. 2011, 2, 187–196. [Google Scholar] [CrossRef]
- Andrade, J.C.; Kumar, S.; Kumar, A.; Černáková, L.; Rodrigues, C.F. Application of probiotics in candidiasis management. Crit. Rev. Food Sci. Nutr. 2021, 22, 1–16. [Google Scholar] [CrossRef] [PubMed]
- Higashikawa, F.; Noda, M.; Awaya, T.; Nomura, K.; Oku, H.; Sugiyama, M. Improvement of constipation and liver function by plant-derived lactic acid bacteria: A double-blind, randomized trial. Nutrition 2010, 26, 367–374. [Google Scholar] [CrossRef] [Green Version]
- Zhao, X.; Higashikawa, F.; Noda, M.; Kawamura, Y.; Matoba, Y.; Kumagai, T.; Sugiyama, M. The obesity and fatty liver are reduced by plant-derived Pediococcus pentosaceus LP28 in high fat diet-induced obese mice. PLoS ONE 2012, 7, e30696. [Google Scholar] [CrossRef] [Green Version]
- Higashikawa, F.; Noda, M.; Awaya, T.; Danshiitsoodol, N.; Matoba, Y.; Kumagai, T.; Sugiyama, M. Anti-obesity effect of Pediococcus pentosaceus LP28 on overweight subjects: A randomized, double-blind, placebo-controlled clinical trial. Eur. J. Clin. Nutr. 2016, 70, 582–587. [Google Scholar] [CrossRef]
- Noda, M.; Sultana, N.; Hayashi, I.; Fukamachi, M.; Sugiyama, M. Exopolysaccharide produced by Lactobacillus paracasei IJH-SONE68 prevents and improves the picryl chloride-induced contact dermatitis. Molecules 2019, 24, 2970. [Google Scholar] [CrossRef] [Green Version]
- Noda, M.; Maruyama, M.; Danshiitsoodol, N.; Higashikawa, F.; Sugiyama, M. Improvement of alcohol-poisoning symptoms in mice by the oral administration of live Lactobacillus plantarum SN13T cells. Int. J. Mol. Sci. 2020, 21, 1896. [Google Scholar] [CrossRef] [PubMed] [Green Version]
- Noda, M.; Miyauchi, R.; Danshiitsoodol, N.; Higashikawa, F.; Kumagai, T.; Matoba, Y.; Sugiyama, M. Characterization and mutational analysis of a two-polypeptide bacteriocin produced by citrus iyo-derived Lactobacillus brevis 174A. Biol. Pharm. Bull. 2015, 38, 1902–1909. [Google Scholar] [CrossRef] [PubMed] [Green Version]
- Danshiitsoodol, N.; Yamashita, H.; Noda, M.; Kumagai, T.; Matoba, Y.; Sugiyama, M. Aspergillus oryzae S-03 produces gingipain inhibitors as a virulence factor for Porphyromonas gingivalis. J. Bacteriol. Virol. 2014, 44, 152–161. [Google Scholar] [CrossRef] [Green Version]
- Okahashi, N.; Asakawa, H.; Koga, T.; Masuda, N.; Hamada, S. Clinical isolates of Streptococcus mutans serotype c with altered colony morphology due to fructan synthesis. Infect. Immun. 1984, 44, 617–622. [Google Scholar] [CrossRef] [PubMed] [Green Version]
- Matsumura, M.; Izumi, T.; Matsumoto, M.; Tsuji, M.; Fujiwara, T.; Ooshima, T. The Role of glucan-binding proteins in the cariogenicity of Streptococcus mutans. Microbiol. Immunol. 2003, 47, 213–215. [Google Scholar] [CrossRef]
- Yamaguchi, M.; Terao, Y.; Ogawa, T.; Takahashi, T.; Hamada, S.; Kawabata, S. Role of Streptococcus sanguinis sortase A in bacterial colonization. Microbes. Infect. 2006, 8, 2791–2796. [Google Scholar] [CrossRef]
- Pedersen, K. Method for studying microbial biofilms in flowing-water systems. Appl. Environ. Microbiol. 1982, 43, 6–13. [Google Scholar] [CrossRef] [Green Version]
- Hiraishi, A. Direct automated sequencing of 16S rDNA amplified by polymerase chain reaction from bacterial cultures without DNA purification. Lett. Appl. Microbiol. 1992, 15, 210–213. [Google Scholar] [CrossRef] [PubMed]
- Lane, D.J. 16S/23S rRNA sequencing. In Nucleic Acid Techniques in Bacterial Systematics; Stackebrandt, E., Goodfellow, M., Eds.; John Wiley and Sons: Chichester, UK, 1991; pp. 115–175. [Google Scholar]
- Weisburg, W.; Barns, S.; Pelletier, D.; Lane, D. 16S ribosomal DNA amplification for phylogenetic study. J. Bacteriol. 1991, 173, 697–703. [Google Scholar] [CrossRef] [PubMed] [Green Version]
- Altschul, S.F.; Gish, W.; Miller, W.; Myers, E.W.; Lipman, D.J. Basic local alignment search tool. J. Mol. Biol. 1990, 215, 403–410. [Google Scholar] [CrossRef]
- DuBois, M.; Gilles, K.A.; Hamilton, J.K.; Rebers, P.A.; Smith, F. Colorimetric method for determination of sugars and related substances. Anal. Chem. 1956, 28, 350–356. [Google Scholar] [CrossRef]
- Albersheim, P.; Nevins, D.J.; English, P.D.; Karr, A. A method for the analysis of sugars in plant cell-wall polysaccharides by gas-liquid chromatography. Carbohydr. Res. 1967, 5, 340–345. [Google Scholar] [CrossRef]
- Sakura, A.; Suzuki, S.; Satoh, T. Improvement of the Ames test using human liver S9 preparation. In Optimization in Drug Discovery: In Vitro Methods. Methods in Pharmacology and Toxicology; Yan, Z., Caldwell, G., Eds.; Humana Press: Totowa, NJ, USA, 2004; pp. 325–336. [Google Scholar]
- Reck, M.; Tomasch, J.; Wagner-Döbler, I. The alternative sigma factor SigX controls bacteriocin synthesis and competence, the two quorum sensing regulated traits in Streptococcus mutans. PLoS Genet. 2015, 11, e1005353. [Google Scholar] [CrossRef]
- Yoshida, A.; Kuramitsu, H.K. Multiple Streptococcus mutans genes are involved in biofilm formation. Appl. Environ. Microbiol. 2002, 68, 6283–6291. [Google Scholar] [CrossRef] [Green Version]
- Wenderska, I.B.; Lukenda, N.; Cordova, M.; Magarvey, N.; Cvitkovitch, D.G.; Senadheera, D.B. A novel function for the competence inducing peptide, XIP, as a cell death effector of Streptococcus mutans. FEMS Microbiol. Lett. 2012, 336, 104–112. [Google Scholar] [CrossRef] [PubMed] [Green Version]
- Eick, S.; Lussi, A. Arginine: A weapon against cariogenic biofilm? Monogr. Oral Sci. 2021, 29, 80–90. [Google Scholar]
- Gu, S.L.; Gong, Y.; Zhang, J.; Chen, Y.; Wu, Z.; Xu, Q.; Fang, Y.; Wang, J.; Tang, L.L. Effect of the short-term use of fluoroquinolone and β-lactam antibiotics on mouse gut microbiota. Infect. Drug Resist. 2020, 13, 4547–4558. [Google Scholar] [CrossRef]
- Aoki, H.; Shiroza, T.; Hayakawa, M.; Sato, S.; Kuramitsu, H.K. Cloning of a Streptococcus mutans glucosyltransferase gene coding for insoluble glucan synthesis. Infect. Immun. 1986, 53, 587–594. [Google Scholar] [CrossRef] [Green Version]
- Hanada, N.; Kuramitsu, H.K. Isolation and characterization of the Streptococcus mutans gtfC gene, coding for synthesis of both soluble and insoluble glucans. Infect. Immun. 1988, 56, 1999–2005. [Google Scholar] [CrossRef] [PubMed] [Green Version]
- Hanada, N.; Kuramitsu, H.K. Isolation and characterization of the Streptococcus mutans gtfD gene, coding for primer-dependent soluble glucan synthesis. Infect. Immun. 1989, 57, 2079–2085. [Google Scholar] [CrossRef] [PubMed] [Green Version]
- Yoshida, A. Quorum sensing by oral bacteria and biofilm formation. J. Environ. Biotech. 2010, 10, 9–14. [Google Scholar]
- Yoshida, A.; Ansai, T.; Takehara, T.; Kuramitsu, H.K. LuxS-based signaling affects Streptococcus mutans biofilm formation. Appl. Environ. Microbiol. 2005, 71, 2372–2380. [Google Scholar] [CrossRef] [Green Version]
- Tahmourespour, A.; Salehi, R.; Kasra Kermanshahi, R. Lactobacillus acidophilus-derived biosurfactant effect on gtfB and gtfC expression level in Streptococcus mutans biofilm cells. Braz. J. Microbiol. 2011, 42, 330–339. [Google Scholar] [CrossRef] [Green Version]
- Wu, C.C.; Lin, C.T.; Wu, C.Y.; Peng, W.S.; Lee, M.J.; Tsai, Y.C. Inhibitory effect of Lactobacillus salivarius on Streptococcus mutans biofilm formation. Mol. Oral Microbiol. 2015, 30, 16–26. [Google Scholar] [CrossRef]
- Jang, H.J.; Kim, J.H.; Lee, N.-K.; Paik, H.-D. Inhibitory effects of Lactobacillus brevis KU15153 against Streptococcus mutans KCTC 5316 causing dental caries. Microb. Pathog. 2021, 157, 104938. [Google Scholar] [CrossRef] [PubMed]
- Wenderska, I.B.; Cordova, M.; Cvitkovitch, D.G.; Senadheera, D.B. The Regulatory Role of ComRS in Cell Viability and Biofilm Formation of Streptococcus mutans. In Proceedings of the University of Toronto Faculty of Dentistry’s Research Day 2013, Toronto, ON, Canada, 12 February 2013; Abstract 52. p. 34. [Google Scholar]
- Wenderska, I.B.; Cvitkovitch, D.G.; Senadheera, D.B. Regulation of Streptococcus mutans biofilm formation by competence signaling networks. In Proceedings of the AADR/CADR Meeting, Charlotte, NC, USA, 22 March 2014. Abstract 1525. [Google Scholar]
- Panthavee, W.; Noda, M.; Danshiitsoodol, N.; Kumagai, T.; Sugiyama, M. Characterization of exopolysaccharides produced by thermophilic lactic acid bacteria isolated from tropical fruits of Thailand. Biol. Pharm. Bull. 2017, 40, 621–629. [Google Scholar] [CrossRef] [Green Version]
- Noda, M.; Shiraga, M.; Kumagai, T.; Danshiitsoodol, N.; Sugiyama, M. Characterization of the SN35N strain-specific exopolysaccharide encoded in the whole circular genome of a plant-derived Lactobacillus plantarum. Biol. Pharm. Bull. 2018, 41, 536–545. [Google Scholar] [CrossRef] [Green Version]
- Noda, M.; Sugimoto, S.; Hayashi, I.; Danshiitsoodol, N.; Fukamachi, M.; Sugiyama, M. A novel structure of exopolysaccharide produced by a plant-derived lactic acid bacterium Lactobacillus paracasei IJH-SONE68. J. Biochem. 2018, 164, 87–92. [Google Scholar] [CrossRef]
- Kakegawa, H.; Matsumoto, H.; Satoh, T. Activation of hyaluronidase by metallic salts and compound 48/80, and inhibitory effect of anti-allergic agents on hyaluronidase. Chem. Pharm. Bull. 1985, 33, 642–646. [Google Scholar] [CrossRef] [PubMed] [Green Version]
- Fujitani, N.; Sakaki, S.; Yamaguchi, Y.; Takenaka, H. Inhibitory effects of microalgae on the activation of hyaluronidase. J. Appl. Phycol. 2001, 13, 489–492. [Google Scholar] [CrossRef]
- Maeda, Y.; Yamamoto, M.; Masui, T.; Sugiyama, K.; Yokota, M.; Nakagomi, K.; Tanaka, H.; Takahashi, I.; Kobayashi, T.; Kobayashi, E. Inhibitory effect of tea extracts on hyaluronidase. Shokuhin Eiseigaku Zashi 1990, 31, 233–237. [Google Scholar] [CrossRef]
- Loesche, W.J. Role of Streptococcus mutans in human dental decay. Microbiol. Rev. 1986, 50, 353–380. [Google Scholar] [CrossRef] [PubMed]
- Bowen, W.H. Do we need to be concerned about dental caries in the coming millennium? Crit. Rev. Oral Biol. Med. 2002, 13, 126–131. [Google Scholar] [CrossRef] [PubMed] [Green Version]
- Beighton, D. The complex oral microflora of high-risk individuals and groups and its role in the caries process. Community Dent. Oral Epidemiol. 2005, 33, 248–255. [Google Scholar] [CrossRef]

| Name | Sequence (5′→3′) | Target |
|---|---|---|
| gtfB-F | ACTTTCGGGTGGCTTGGTT | gtfB |
| gtfB-R | GCTTAGATGTCGCTTCGGTTG | gtfB |
| gtfC-F | CCATGACAGTGAAGTGCAGGA | gtfC |
| gtfC-R | CCATAGTGAAAGAATACCCGACAAC | gtfC |
| gtfD-F | AAGGCGGTGCTCTGCTTTAT | gtfD |
| gtfD-R | ACTGGTTGGTGTGCGGTTC | gtfD |
| gyrA-F | ACAGAAGCGCGTATGAGCAA | gyrA |
| gyrA-R | TGTCGCTCCATTAACCAGAAGA | gyrA |
Publisher’s Note: MDPI stays neutral with regard to jurisdictional claims in published maps and institutional affiliations. |
© 2021 by the authors. Licensee MDPI, Basel, Switzerland. This article is an open access article distributed under the terms and conditions of the Creative Commons Attribution (CC BY) license (https://creativecommons.org/licenses/by/4.0/).
Share and Cite
Noda, M.; Sugihara, N.; Sugimoto, Y.; Hayashi, I.; Sugimoto, S.; Danshiitsoodol, N.; Sugiyama, M. Lactobacillus reuteri BM53-1 Produces a Compound That Inhibits Sticky Glucan Synthesis by Streptococcus mutans. Microorganisms 2021, 9, 1390. https://doi.org/10.3390/microorganisms9071390
Noda M, Sugihara N, Sugimoto Y, Hayashi I, Sugimoto S, Danshiitsoodol N, Sugiyama M. Lactobacillus reuteri BM53-1 Produces a Compound That Inhibits Sticky Glucan Synthesis by Streptococcus mutans. Microorganisms. 2021; 9(7):1390. https://doi.org/10.3390/microorganisms9071390
Chicago/Turabian StyleNoda, Masafumi, Naho Sugihara, Yoshimi Sugimoto, Ikue Hayashi, Sachiko Sugimoto, Narandalai Danshiitsoodol, and Masanori Sugiyama. 2021. "Lactobacillus reuteri BM53-1 Produces a Compound That Inhibits Sticky Glucan Synthesis by Streptococcus mutans" Microorganisms 9, no. 7: 1390. https://doi.org/10.3390/microorganisms9071390






